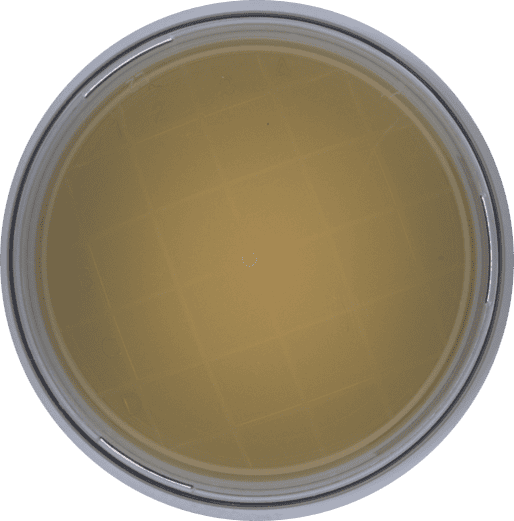
Microtechnix | EMMA | Digitize Microbiology QC

EMMA electronic ReezaFLATzitzⅡ ディストーション ディストーション ReezaFRATzitz 2 emma electronic
(3115件)
Pontaパス特典
サンキュー配送
7424円(税込)
75ポイント(1%)
Pontaパス会員ならさらに+1%ポイント還元!
送料
(
)
3102
配送情報
お届け予定日:2026.04.09 13:37までにお届け
※一部地域・離島につきましては、表示のお届け予定日期間内にお届けできない場合があります。
ロットナンバー
47036210033
お買い物の前にチェック!

Pontaパス会員なら
ポイント+1%
ポイント+1%
商品説明

EMMA electronicのReezaFLATzitzⅡです。機材入れ替えのため出品致します。2バンドイコライザーがついていて音作りの幅も広くかなり使いやすいギター用ディストーションになります。gain幅も広くオーバードライブからかなりベビーなディストーションまでカバーできるます。当方はJCに繋いで使用していました。程よいチューブ感があり、コンプ感がとても気持ちよく良いリードサウンドを作ることができました。ジャズコのトランジスタ感を消すのに打って付けだと思います。少々ドンシャリ気味なのですが、BIASツマミを回すことで中域のコントロールができ、楽に音作りができました。背面にベルクロを貼った後がございますがご了承ください。この機会にぜひご検討ください。ご覧いただきありがとうございます。
| カテゴリー: | ホビー・楽器・アート>>>ギター>>>ギターエフェクター |
|---|---|
| 商品の状態: | 目立った傷や汚れなし","細かな使用感・傷・汚れはあるが、目立たない |
| 配送料の負担: | 送料込み(出品者負担) |
| 配送の方法: | 佐川急便/日本郵便 |
| 発送元の地域: | 徳島県 |
| 発送までの日数: | 4~7日で発送 |
レビュー
商品の評価:




 4.4点(3115件)
4.4点(3115件)
- 189696
- 大正解です!!4歳の息子にブルーをプレゼントしました。 ギター大好きな息子。最近おもちゃのギターでは物足りなくなっていたようなので、これに決めました。箱を開けた瞬間、あまりのカッコよさに固まっていました!
- raya2011
- 3歳の息子がサンタさんからギターを貰うと言うので、検索しこちらで購入させていただきました。最初はどうしたらいいか分からなかった本人も今では自分なりに楽しそうに遊んでいます。プレゼント用に包装はしていただけたのですが、プチプチに包んで郵送されてきたので中が丸見え‥受け取りの場に息子がいなくてよかった。
- ゆう月姫
- 子供が二人いますが、上の娘に色違いの同じギターを買っていました。そのギターは、値段と小ささの割には結構精度がよく、大人が弾いても普通に使えるギターだったので、息子にもクリスマスプレゼントとして購入。息子はとても喜んでくれました!
- momohana1109
- 3歳になる子どもの誕生日にパパが本格的なギターをあげたいというので。即納でとても満足していますが、ラッピングをして頂けると、尚、良かったと思います。
- あき42024744
- 子供の自由研究用に・・・と思いましたが、小学校2年生にはまだちょっと難しかったようで父親の手を借りて完成させました。 木工用ボンドできれいに組み立てたり弦を張ったりは少々早かったようです^^; 小学校高学年には良いかもです^^
すべて見る
お店の情報
7,367
連絡・応対
4.3
配送スピード
4.3
梱包
4.3